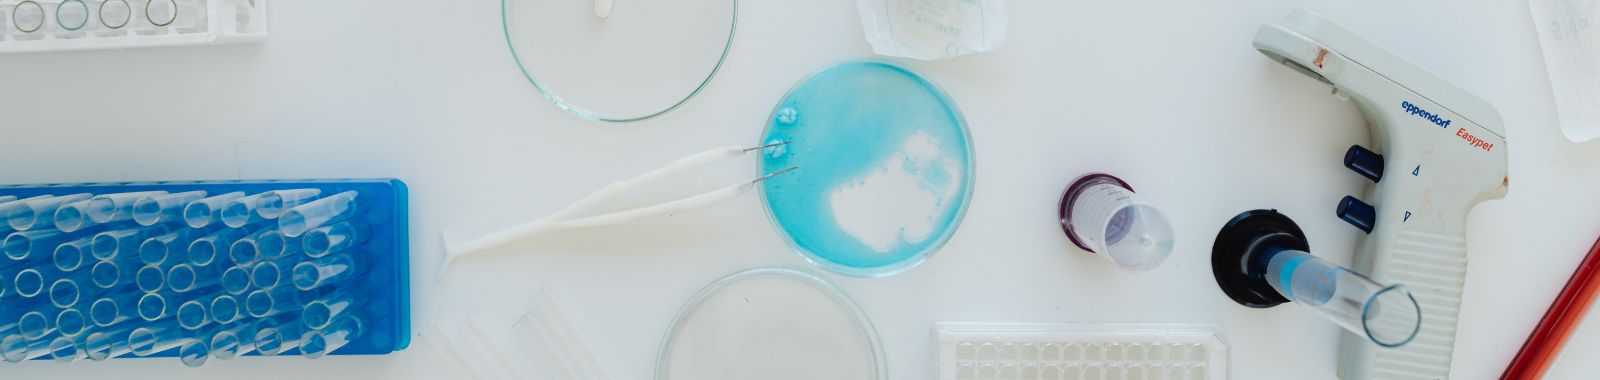

Understanding the "Why": The Importance of Antimicrobial Efficacy Testing for Consumer Safety
Global expertise, personal touch
Have you ever wondered what ensures that your everyday products—like creams, shampoos, hospital fabrics, or even disinfectants—are truly safe from harmful microbes?
The fact is that, in the absence of proper protection, many of the goods we use daily would serve as breeding grounds for bacteria, fungi, and other microorganisms. That is why antimicrobial efficacy testing is so significant. Scientific support safeguards the consumer, ensures product safety, and verifies the claims made by business organisations about their products.
The antimicrobial textiles market is growing at an impressive rate and is expected to reach USD 29.27 billion by 2032. As this demand grows, it becomes very important to verify the effectiveness of the fabrics. An effective test enables antimicrobial textiles to effectively halt microbial proliferation, thereby offering products that not only meet consumer expectations but also ensure their health and safety.
Antimicrobial testing is no longer optional in the modern world, where consumers are seeking both quality and safety. We will discuss the importance of these tests, the guidelines on which they are based, and the role that they serve in consumer trust and welfare.
What is an Antimicrobial Efficacy Test?
An antimicrobial efficacy test is a laboratory test that identifies the level of effectiveness of a product in killing or preventing microorganisms (bacteria, fungi, yeast, and moulds).
For example:
- A hand sanitiser should demonstrate its ability to eliminate dangerous bacteria and viruses in a short period of time.
- An antimicrobial preservative efficacy test should be conducted on a cosmetic cream to ensure that preservatives can maintain their inhibitory effect on microbial growth throughout the product's shelf life.
- To minimise the risk of infection, a hospital fabric should prove to be resistant to microbial contamination.
The test is not only about demonstrating performance at launch — it also guarantees continued protection in the real world during operation and storage.
The Importance of Antimicrobial Efficacy Testing
Antimicrobial efficacy testing is crucial to verify that items claimed to provide a barrier against harmful microbes are indeed effective, safe, and reliable for consumer use.
- Protects Consumers
Infectious, irritating, or even dangerous diseases can result from contaminated products. These risks are reduced through antimicrobial efficacy testing.
- Meets Regulatory Standards
The world needs testing. EPA antimicrobial efficacy testing is used to validate disinfectants in the U.S., while antimicrobial efficacy test USP and antimicrobial efficacy test EP verify pharmaceutical and cosmetic products under the American and European pharmacopoeias.
- Builds Trust
Brands demonstrate the effectiveness of their products through antimicrobial testing and preservative efficacy testing, which fosters long-term consumer loyalty.
- Extends Shelf Life
It has been demonstrated that the preservatives remain effective up to the product's expiry date, thereby preventing waste and maintaining the product's integrity.
Types of Antimicrobial Efficacy Testing
- Test of antimicrobial efficacy, USP - Pharmaceuticals and cosmetics, United States.
- Antimicrobial efficacy test EP - mandatory in Europe for similar products.
- EPA antimicrobial efficacy testing - Confirms that disinfectants and sanitisers are as good as they claim to be.
- Antimicrobial preservative effects test - verifies that the preservatives will not lose their effectiveness against the growth of microbes during the shelf life period.
- Antimicrobial efficacy and preservative efficacy testing - Tests the short-term antimicrobial activity and the long-term preservative activity.
Standard Testing Methods
Not all products would need the same testing. Some of the best known are:
- AATCC 100 - CFU Reduction Test, Quantitative.
Determines how much bacteria have been reduced on fabric in more than 24 hours. Ordinary absorbent fabrics such as hospital gowns and sportswear. - ISO 20743 - Textile Testing
Offers the ability to test the antimicrobial performance of textiles, such as clothing, bedding, or padding, in multiple ways. - ASTM E2149 - Dynamic Contact Test
The simulation of real-life conditions is achieved by testing antimicrobial performance under agitation with constant movement, which is applied to non-absorbent or uneven materials.
Real-World Applications
- Healthcare and Pharmaceuticals
Antimicrobial products are used daily in hospitals. Antimicrobial efficacy testing assures that syringes and creams, bed linens, and gowns are sterile and safe.
- Cosmetics and Personal Care
Antimicrobial preservative efficacy testing is necessary for products such as lotions, sunscreens, and shampoos to ensure that preservatives are effective in inhibiting microbial proliferation with repeated use.
- Textiles and Fabrics
Activewear, baby clothes, and home linens are tested, including antimicrobial efficacy tests, to ensure odour control, hygiene, and safety.
- Home and commercial Cleaners
Before disinfectants and surface cleaners are offered to their consumers, they should have undergone EPA antimicrobial efficacy tests.
- Food and Beverage Packaging
Packaging materials are subjected to tests that test their resistance to microbial contamination in storage and distribution.
Benefits Beyond Consumer Safety
Antimicrobial efficacy testing not only safeguards the user but is also beneficial to the manufacturer:
- Market Acceptance - Products are tested, and once passed, they are sold in controlled markets.
- Fewer Recalls - eliminates expensive, reputation-destroying recalls.
- Brand Value - Cultivates confidence in consumers through proven performance.
- Endorses Innovation - Allows manufacturers to have plausible claims regarding new antimicrobial technology.
Challenges in Antimicrobial Efficacy Testing
- Various Standards in the World - USP, EP, and EPA standards differ, and this poses a disadvantage to multinational companies.
- Costs and Time - Fully testing it may be resource-consuming.
- Changing Microorganisms - As these microbes evolve, the test methods must also evolve to remain effective.
All these difficulties notwithstanding, it is not possible to skip antimicrobial testing. The safety of consumers and brand image is too expensive.
Final Thoughts
The importance of antimicrobial efficacy testing cannot be overstated—it safeguards consumer health, ensures compliance, and builds trust. In a market saturated with antimicrobial claims, the only way to distinguish true from false is through thorough testing.
Companies that are fully committed to producing high-quality and safe products will not miss the opportunity to partner with Eurofins C&PC to obtain the right products that offer both safety and effectiveness.
In the final analysis, scientific evidence is where consumer confidence starts - and antimicrobial efficacy testing is the instrument that makes that confidence possible.
Frequently Asked Questions
- What does the antimicrobial efficacy testing do?
Antimicrobial efficacy tests confirm that a product is capable of killing or preventing the growth of microorganisms, such as bacteria, fungi, and mould. It is a guarantee of safety, regulatory, and brand credibility. - What products need antimicrobial efficacy testing?
Antimicrobial efficacy tests are conducted on products such as disinfectants, hospital fabrics, cosmetics, pharmaceuticals, personal care products, activewear, and even food packaging to ensure that they are safe and effective. - What is the advantage of antimicrobial efficacy testing to manufacturers?
Manufacturers establish a presence in the market, minimise the chances of recall, build a brand name, and can promote new antimicrobial technologies without fear. - What is the reason why antimicrobial testing is increasingly becoming significant today?
As consumers increasingly demand safe and hygienic products, microbes adapt, and regulations tighten, testing antimicrobial efficacy has become a necessity to ensure quality and confidence. - What are the major international standards of antimicrobial testing?
The most general standards are:
-
- Pharmaceutical and cosmetic USP (United States Pharmacopoeia).
- EP (European Pharmacopoeia) to European markets.
- EPA (Environmental Protection Agency, USA) disinfectants and sanitisers.
- Textile and fabric AATCC 100, ISO 20743, and ASTM E2149.